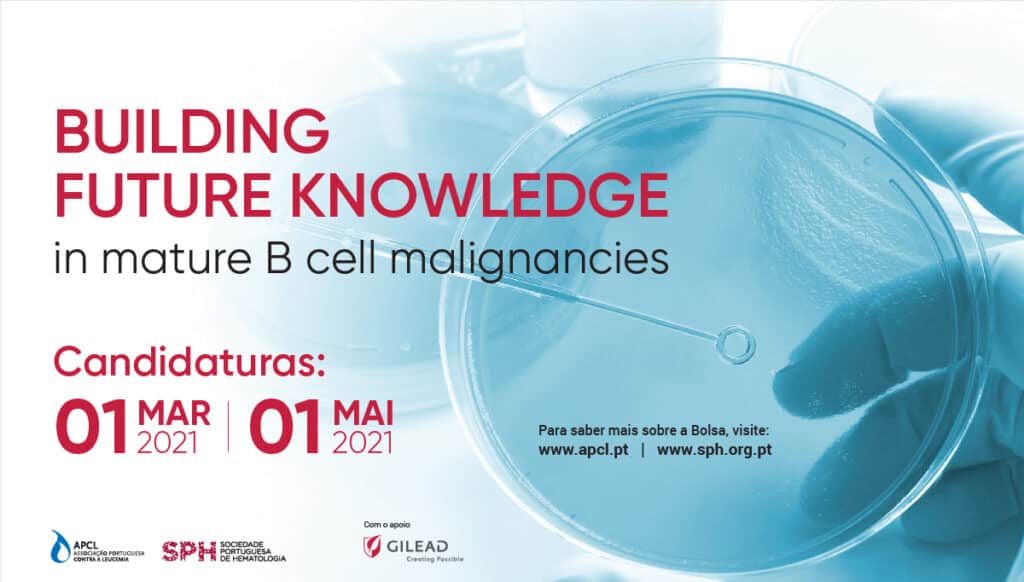

As candidaturas à 3.ª edição da bolsa “Building Future Knowledge in mature B cell malignacies” continuam abertas e encerram no dia 1 de maio. Esta é uma iniciativa promovida pela Associação Portuguesa Contra a Leucemia (APCL) e pela Sociedade Portuguesa de Hematologia (SPH), com apoio da biofarmacêutica Gilead Sciences, que tem como objetivo distinguir o projeto de investigação em neoplasias de células B maduras mais promissor.
A bolsa, no valor de 15 mil euros, destina-se a projetos com a duração máxima de um ano. Podem candidatar-se todos os investigadores nacionais ou estrangeiros, desde que os projetos estejam a ser desenvolvidos em instituições portuguesas. Serão valorizados projetos de caráter interdisciplinar e de colaboração entre instituições que se dediquem ao estudo das áreas do tratamento, diagnóstico, epidemiologia, qualidade de vida dos doentes e impacto a nível sociológico. As candidaturas podem ser submetidas por email para bolsas@apcl.pt e o regulamento pode ser consultado no website da APCL.
“Mesmo no ano atípico que estamos a viver, não podíamos deixar de apoiar estes projetos, sendo isto um dos pilares do nosso trabalho diário. Mais uma vez, demonstramos assim o nosso compromisso em contribuir para a investigação das doenças hemato-oncológicas malignas”, afirma Manuel Abecasis, presidente da APCL, que desde 2003 já atribuiu mais de 450 mil euros em bolsas de investigação.
A mesma ideia é sublinhada por João Raposo, presidente da SPH, que refere ainda que “a Hemato-oncologia é das áreas oncológicas com maior taxa de sucesso na cura definitiva de um número bastante expressivo de doentes. Para mantermos essa taxa de cura é necessário continuar a fomentar e incentivar a investigação com projetos como esta bolsa que com tanta satisfação apoiamos.”
Por sua vez, Vítor Papão, Diretor Geral da Gilead Sciences Portugal, refere que “esta é a terceira vez que a Gilead apoia esta iniciativa, porque acreditamos na importância da promoção da investigação nacional na área das doenças hemato-oncológicas”.
A coordenadora do projeto vencedor da primeira edição da bolsa, Sara Duarte, médica de Hematologia no Centro Hospitalar e Universitário de Coimbra (CHUC), considera que este é “um prémio que deu grande apoio ao nosso projeto e que nos dará a possibilidade de iniciar trabalhos posteriores mais vastos”, sendo que, no seu caso, o objetivo passou principalmente pelo uso deste “suporte financeiro nos estudos de citometria de fluxo”.
Este projeto, distinguido com a bolsa no valor de 15 mil euros, foca-se no Linfoma Linfoplasmocitico/Macroglobulinémia de Waldenstrom, um tipo de linfoma não Hodgkin, que não é muito frequente e caracterizado, pertencendo ao grupo dos linfomas indolentes.






